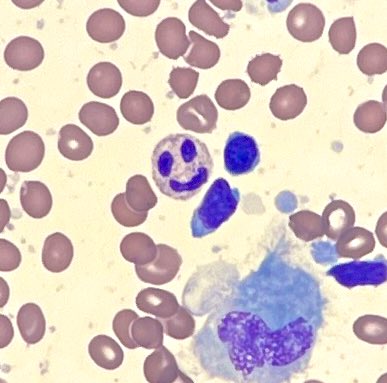
Spotted the happiest little fella down the microscope today #pathology #histopathology #haematopathology #olympus #pathologytraining <a href="/RCPath/">RC of Pathologists</a>

Chuer Zhang
@chuerzhang
NHS trainee pathologist, with interest in research and digital pathology ✝️🐱🏸🎗️🔬🧬🖋️🍫🌻
ID: 543567979
02-04-2012 17:06:17
125 Tweet
74 Takipçi
161 Takip Edilen

Great evening at RC of Pathologists ceremony! Felt humbled to be in the presence of people who have achieved so much when I've just done 2 months of ST1, but more motivated to work hard now! #pathology #histopathology #nhs #thesciencebehindthecure


Inspiring night at RC of Pathologists New Fellows ceremony and humbled to have met the amazing Dame Lesley Regan Thank you for your kind and encouraging words




The club of the year award goes to Chelsea FC ! #ballondor









Today’s risible pay announcement is nothing less than a betrayal of the profession. It leaves junior doctors in England no choice but to press ahead with preparations for a ballot for industrial action. Statement from Sarah Hallett @MikeJKemp bma.org.uk/bma-media-cent…






Spotted the happiest little fella down the microscope today #pathology #histopathology #haematopathology #olympus #pathologytraining RC of Pathologists